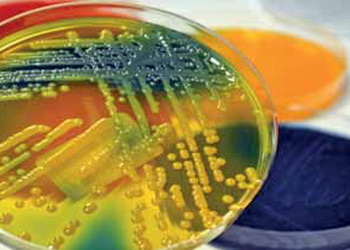

Діагноз на клебсієльоз птиці не підтверджується лише за результатами розтину
За клебсієльозу у птиці спостерігають такі патологоанатомічні зміни: фібринозний аеросакуліт, катарально-фібринозна пневмонія, гепатоспленомегалія, точкові крововиливи на серозних оболонках, катаральний ентерит.
Про це пише журнал «Наше птахівництво».
Зміни ‒ непатогномонічні, й діагноз не можна підтвердити лише за результатами розтину птиці. Тому лабораторне діагностування є ключовим етапом.
Для дослідження направляють: печінку, селезінку, легені; ексудат із повітроносних мішків; кров серця (за септицемії); мазки з трахеї й клоаки.
Під час бактеріологічного дослідження роблять посів на МПА, Ендо, Макконки. Характерними є великі слизові колонії, за мікроскопії ‒ грамнегативні нерухомі палички. Капсульна реакція позитивна. Збудник ферментує лактозу, дає негативну оксидазну реакцію. Для підтвердження виду ставлять індол-пробу: K. рneumoniae ‒ негативна, K. оxytoca ‒ позитивна.
Для встановлення діагнозу на клебсієльоз важливо використовувати молекулярні методи, а саме ПЛР-діагностування. Це особливо актуально за змішаних інфекцій.
Обов’язковим етапом діагностування є визначення чутливості до антибактеріальних препаратів. Без антибіотикограми лікування часто неефективне.
Клебсієльоз диференціюють із колібактеріозом (ешерихіозом), пастерельозом, мікоплазмозом, орнітобактеріозом, сальмонельозом. Остаточний діагноз установлюють лише на підставі лабораторного підтвердження.
Діагноз «клебсієльоз птиці» вважають підтвердженим за наявності таких критеріїв: виділення культури Klebsiella spp., ідентифікація збудника, наявність характерних епізоотологічних і клініко-патологоанатомічних даних, визначення чутливості збудника до антибіотиків.